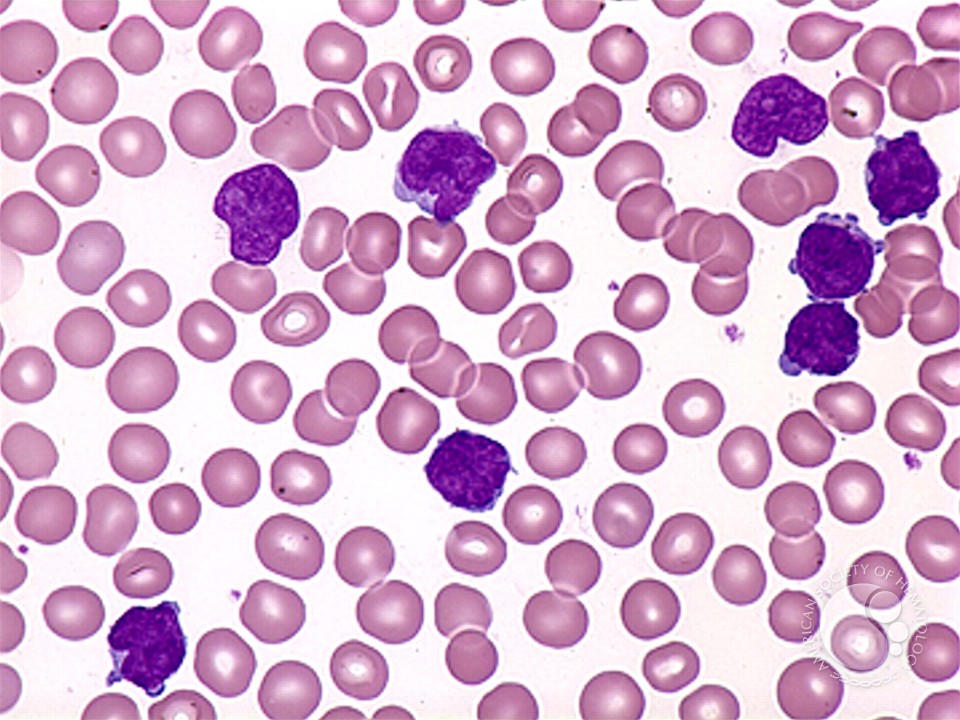

What is T-Cell Prolymphocytic Leukemia?
T-Cell Prolymphocytic Leukemia (T-PLL) is a rare and aggressive type of leukemia affecting mature T-lymphocytes, a kind of white blood cell important for the immune system. It leads to the rapid growth of abnormal T-cells in the blood, bone marrow, and other organs.
What Causes T-Cell Prolymphocytic Leukemia?
The exact cause is unknown, but it involves genetic mutations that lead to uncontrolled growth of T-cells. Risk factors may include:
- Older age (typically over 60 years)
- Previous exposure to radiation or chemotherapy (rarely)
- Genetic abnormalities affecting T-cell regulation
It is not inherited or contagious.
What Are the Symptoms of T-Cell Prolymphocytic Leukemia?
Symptoms develop quickly and may include:
- Fatigue and weakness due to anemia
- Enlarged lymph nodes, liver, or spleen
- Frequent infections from low healthy white blood cells
- Easy bruising or bleeding from low platelets
- Weight loss and night sweats
Symptoms reflect the rapid spread of abnormal cells.
How is T-Cell Prolymphocytic Leukemia Diagnosed?
Diagnosis involves:
- Blood tests showing high numbers of abnormal T-cells
- Bone marrow biopsy to assess disease extent
- Immunophenotyping to identify T-cell markers
- Genetic tests to detect chromosomal abnormalities
- Imaging to check organ involvement
Early diagnosis guides treatment planning.

How is T-Cell Prolymphocytic Leukemia Treated?
Treatment options include:
- Chemotherapy to reduce leukemia cells
- Targeted therapies such as monoclonal antibodies
- Stem cell transplantation in eligible patients
- Supportive care to manage symptoms and infections
The disease is often resistant to treatment and requires close monitoring.
Can T-Cell Prolymphocytic Leukemia Be Prevented?
Prevention is not currently possible due to unknown causes. Early detection and prompt treatment may improve outcomes.
When Should You See a Doctor?
Consult a doctor if you experience:
- Persistent fatigue, unexplained weight loss, or frequent infections
- Enlarged lymph nodes or abdominal swelling
- Easy bruising or bleeding


